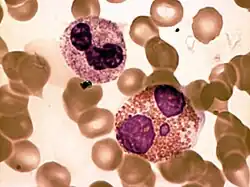

Granulocito

Los granulocitos son células de la sangre (leucocitos), caracterizadas por los modos de colorear los orgánulos (gránulos) de su citoplasma, en microscopía de luz. Según el color con el que quedan tintados, hay tres tipos de granulocitos en la sangre humana:
Sus nombres derivan de las características coloraciones que adoptan por la sustancia que se utiliza para colorear los orgánulos de la célula. El granulocito más abundante es el neutrófilo, cuyos orgánulos se colorean con tintes neutros o casi no adquieren el colorante. Los eosinófilos muestran una importante coloración rojiza y los basófilos muestran afinidad por colorantes básicos, adquiriendo una coloración azulada.
A los granulocitos se les conoce también como leucocitos polimorfonucleares, debido a las formas variables de núcleo que pueden presentar. Sin embargo este término suele ser mal utilizado ya que solo es correcto para los neutrófilos y no para los basófilos ni los eosinófilos.
Además de los granulocitos, los leucocitos se clasifican en agranulocitos.
Una de sus funciones es: que los granulocitos, ayudan al cuerpo a combatir infecciones bacterianas.
Tipos de granulocitos
Los granulocitos se clasifican en neutrófilos, eosinófilos o basófilos, según la coloración que adquieren sus gránulos en la tinción de Giemsa.
Neutrófilos
El neutrófilo es un leucocito (glóbulo blanco), que cuyos gránulos contienen enzimas especializadas en combatir bacterias y hongos. Presentan 3 o 4 lobulaciones.
Eosinófilos
El eosinófilo es un leucocito, con algunas diferencias al anterior; es de tipo granulocito pero sus gránulos no contienen la misma clase de enzimas, sino que combate generalmente parásitos extracelulares y están implicados en respuestas alérgicas. Poseen no más de 4 núcleos que presentan dos lóbulos unidos por una fina hebra de cromatina. Además están provistos de receptores en su exterior, con los cuales interaccionan con otras células.
Basófilos

Los basófilos, presentan generalmente dos núcleos con forma de albóndiga, a menudo cubiertos por gránulos de secreción.